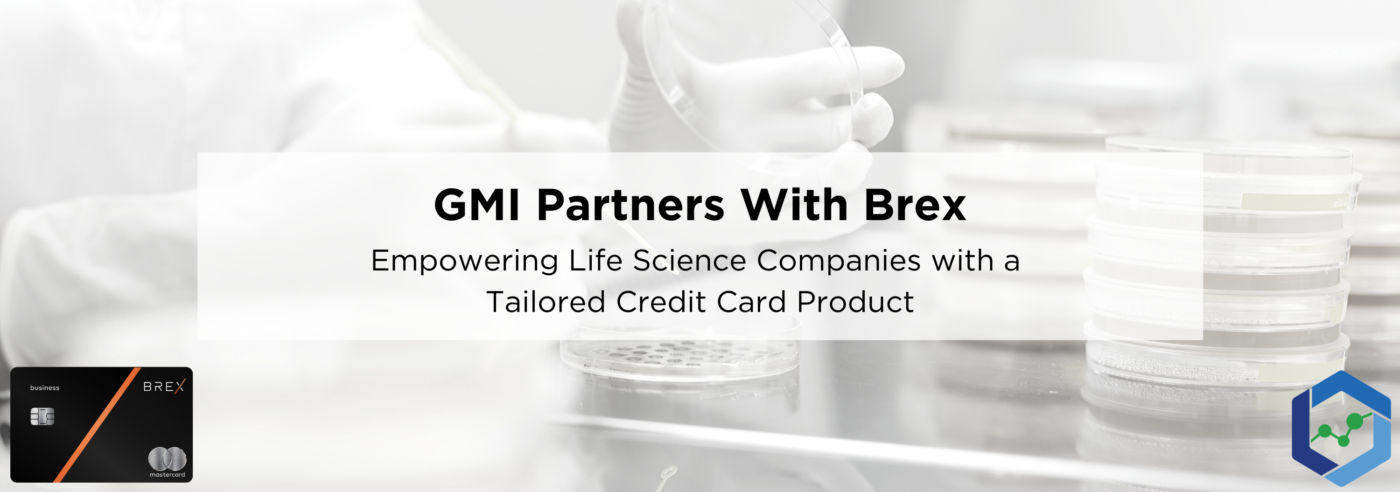
Sliding Headers 6 1400x492 - Empowering Life Sciences Companies with a Tailored Credit Card Product

GMI has partnered with Brex to offer science companies a specifically tailored credit card option!
Tag Archives: centrifuge
Newly found protein is bio-marker for disease could lead to future treatments to slow Alzheimer’s progression
Mice undergoing dietary restriction were better protected against tumors and bacterial infections than those with unrestricted diets, found a new study.
GMI has prepared this simple guide to supplement your understanding on the scientific process of measuring various chemicals and compounds in your cannabis sample.